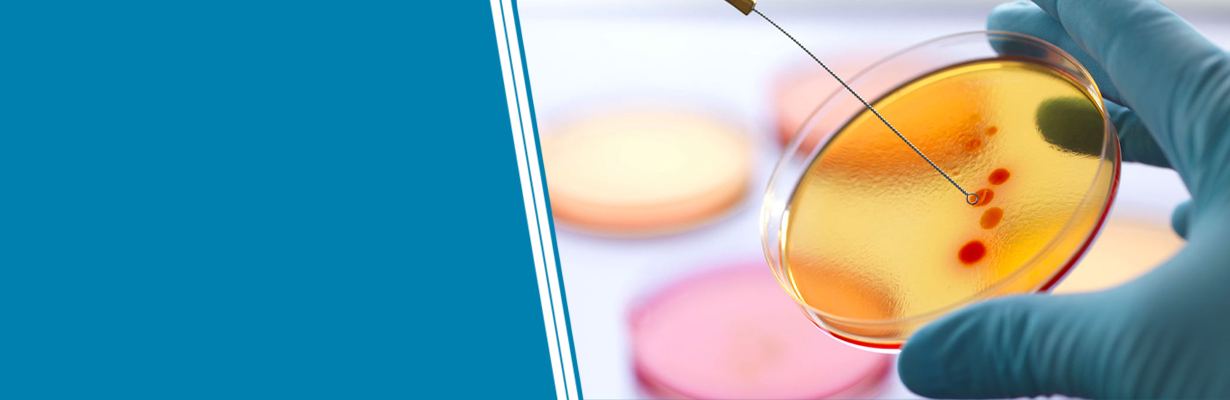
Is Hepatitis C curable?

Dr. KK Aggarwal
Dr. KK Aggarwal
Is Hepatitis C curable?
In this video, Dr. K K Aggarwal, President Heart Care Foundation of India and Group Editor in Chief MEDtalks, will talk whether hepatitis C is curable or not. He confirms that hepatitis C is curable unlike HIV and hepatitis B. it requires a long term management. He will discuss the medication given in Hepatitis C positive patients in details. The treatment is given for three months and the patient should avoid alcohol. He should be also treated for fatty liver and insulin resistance.

Dr. KK Aggarwal
Recipient of Padma Shri, Vishwa Hindi Samman, National Science Communication Award and Dr B C Roy National Award, Dr Aggarwal is a physician, cardiologist, spiritual writer and motivational speaker. He was the Past President of the Indian Medical Association and President of Heart Care Foundation of India. He was also the Editor in Chief of the IJCP Group, Medtalks and eMediNexus


















.jpg)





Please login to comment on this article